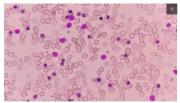

Thalassemia Tak Bisa Disembuhkan?

Mengenal thalassemia lebih jauh
Thalassemia merupakan penyakit darah akibat kelainan pembentukan hemoglobin (Hb). Hemoglobin adalah komponen darah yang bertugas mengikat oksigen dan menjadi “kurir” yang mengantar oksigen untuk jaringan tubuh lain melakukan metabolisme dan beraktivitas. Hemoglobin tidak mampu mempertahankan bentuknya dan mudah pecah, sehingga tidak mampu mengikat dan mengantarkan oksigen ke jaringan yang membutuhkan.
Penyakit ini diturunkan secara genetik. Hal ini bisa terjadi jika ayah, ibu, atau keduanya merupakan carrier atau pembawa gen thalassemia. Thalassemia yang disertai gejala biasanya muncul pada masa anak-anak hingga membutuhkan pengobatan. Ini disebut dengan thalassemia mayor. Sedangkan thalassemia yang tanpa gejala dan tidak membutuhkan pengobatan (biasa disebut sebagai carrier) dikenal dengan thalassemia minor.
Gejala-gejala yang sering muncul seperti kulit kuning dan pucat akibat kurangnya kadar hemoglobin (anemia) dan perut yang membesar juga bisa terjadi. Selain itu, gejala anemia lainnya seperti badan lemas, berdebar, yang jika berlangsung lama dapat mengganggu perkembangan dan pertumbuhan anak. Meskipun begitu, diagnosis thalassemia baru bisa ditegakkan dengan pemeriksaaan darah seperti kadar hemoglobin yang menandakan anemia, total zat besi dalam tubuh, dan lain-lain.
Pada thalassemia, kadar hemoglobin yang rendah membuat tugasnya sebagai kurir oksigen tak berfungsi dengan baik, sehingga oksigen berkurang di berbagai jaringan tubuh. Tentu saja ini berbahaya jika tidak ditangani. Karena, secara keseluruhan tubuh gagal melakukan aktivitas dan metabolismenya.
Seperti orang-orang anemia pada umumnya, pasien thalassemia membutuhkan transfusi darah untuk meningkatkan hemoglobin demi kerja tubuh yang normal. Walaupun demikian, pasien thalassemia perlu transfusi darah sepanjang hidupnya, yang biasanya dilakukan setiap satu bulan sekali. Selain itu, transplantasi sumsum tulang sebagai pabrik darah di tubuh belakangan juga bisa menjadi pengobatan thalassemia.
Tak bisa disembuhkan, tetapi bisa dicegah
Meskipun ada terapi transfusi darah dan transplantasi tulang, tetapi ada efek samping terhadap kesehatan pasien. Misalnya gagal ginjal dan hati. Akibatnya, kualitas hidup pengidap thalassemia menurun, karena biasanya angka harapan hidupnya hanya mencapai usia 20-30 tahun. Meskipun begitu, ada juga pasien yang angka harapan hidupnya mencapai 50 tahun.
Adanya peningkatan angka harapan hidup ini mungkin karena meningkatnya kesadaran masyarajat akan penyakit thalassemia dan deteksi dini.
Salah satu cara mencegah thalassemia adalah dengan melakukan skrining premarital atau pemeriksaan darah sebelum menikah. Tujuannya untuk mengetahui apakah salah satu atau keduanya membawa genetik thalasemia atau tidak. Thalassemia juga bisa diperiksa sejak bayi dalam kandungan.
Thalassemia memang tak bisa disembuhkan. Namun, apabila makin dini penyakit tersebut terdeteksi, kelainan darah ini makin bisa ditangani sehingga kualitas hidup penderita bisa menjadi lebih baik. Menyambut Hari Thalassemia Sedunia perkaya pengetahuan Anda akan penyakit ini.